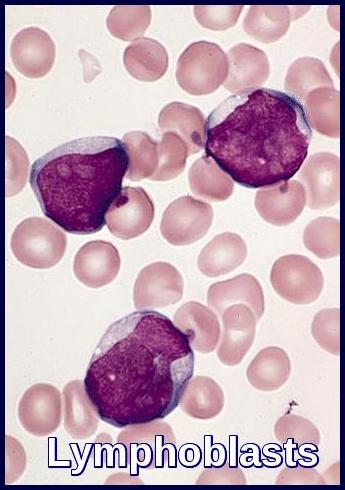
Peripheral blood smear showing lymphoblasts characteristic of Acute Lymphoblastic Leukemia (ALL).

Acute Lymphoblastic Leukemia

Anterior mediastinal mass on chest X-ray commonly seen in T-cell Acute Lymphoblastic Leukemia (ALL).
Acute Lymphoblastic Leukemia (ALL) is an aggressive hematologic malignancy characterized by the uncontrolled proliferation of immature lymphoblasts within the bone marrow and peripheral blood. Without prompt diagnosis and treatment, ALL progresses rapidly, leading to bone marrow failure and life-threatening complications.
The incidence of ALL peaks in early childhood, particularly between ages 2 and 5, accounting for nearly two-thirds of all cases. It is the most common childhood cancer and the second leading cause of cancer-related mortality in children under 15 years of age. In adults, ALL is significantly less frequent than acute myeloid leukemia (AML), yet remains an important cause of acute leukemia–related morbidity.
Epidemiologically, ALL shows a slight male predominance and demonstrates geographic variability, with higher reported incidence rates in countries such as Italy, the United States, Switzerland, and Costa Rica. Understanding these demographic patterns supports earlier recognition, timely referral, and optimized treatment strategies.
Clinical Features:
Acute Lymphoblastic Leukemia usually presents with the symptoms of sudden onset bone marrow failure:
- Anemia with weakness and lethargy.
- Leucopenia with recurrent infections.
- Thrombocytopenia with purpura and bleeding.
- Bone and joint pain may occur.
On examination, lymphadenopathy and hepatosplenomegaly are frequent.
A mediastinal mass may be present on CXR (T-cell ALL).
CNS involvement is rare at presentation though common in late stages of the disease.
Investigations:
- FBC & Blood film.
- Coagulation profile.
- Biochemistry profile including U&Es, LFTs, Bone, LDH, Uric Acid and hematinics.
- CXR.
- CT scan neck, thorax, abdomen and pelvis.
- ECG.
- Echocardiogram.
- Cultures, in particular blood cultures.
- Bone marrow aspirate, trephine, cell markers and cytogenetics.
Anemia is usual. The total leucocyte count is usually raised with Lymphoblasts present. The neutrophil count is usually reduced. The platelet count is usually low.
The bone marrow is hypercellular consisting almost entirely of lymphoblasts. Lymphoblasts generally have a very high nuclear to cytoplasmic ratio. The nuclear chromatin pattern is generally diffuse and there are one or two nucleoli which may be poorly visible.
The lymphoblasts are Sudan black and myeloperoxidase negative (myeloid markers).
Most cases are non-specific esterase negative (granulocytic and especially monocytic marker) although T-cell ALL may show strong polar positivity with esterase or acid phosphatase enzyme staining. The periodic-acid stain (PAS) is often positive.
However, positive confirmation of lymphoid (and not myeloid) lineage should be sought by flow cytometric demonstration of lymphoid antigens, such as CD3 (T-lineage ALL) or CD19 (B-lineage ALL), in order to avoid confusion with some types of myeloid leukemia (eg, M0), which also stain negative with myeloperoxidase (MPO).

Bone marrow aspirate demonstrating extensive lymphoblast infiltration in Acute Lymphoblastic Leukemia (ALL).
Bone marrow aspiration and biopsy are the definitive diagnostic tests to confirm the diagnosis of ALL. Immunophenotyping helps to elucidate the subtype.
Aspiration slides should be stained for morphology with either Wright or Giemsa stain. The diagnosis of ALL is made when at least 30% lymphoblasts (French-American-British [FAB] classification) or 20% lymphoblasts (World Health Organization [WHO] classification) are present in the bone marrow and/or peripheral blood.
In addition, slides should be stained with myeloperoxidase (MPO) and terminal deoxynucleotidyl transferase (TdT), unless another method is used, such as flow cytometry.
Hematoxylin and eosin (H&E)–stained bone marrow core biopsy and clot sections should also be morphologically assessed.
Bone marrow samples should be sent for flow cytometry and cytogenetics. Approximately 15% of patients with ALL have a t(9;22) translocation (Philadelphia chromosome), but other chromosomal abnormalities may also occur, such as t(4;11), t(2;8), and t(8;14).
Classification of Acute Lymphoblastic Leukemia:
ALL can be divided into three types based on morphological criteria (FAB):

FAB L1, L2, and L3 morphological subtypes of Acute Lymphoblastic Leukemia (ALL) with their relative childhood incidence.
L1: Most cells are small with little cytoplasm and indistinct nucleoli. This is the most common variety.
L2: Cells tend to be larger with relatively more cytoplasm. Nuclei often clefted with prominent nucleoli.
L3: Large blasts with very blue cytoplasm with prominent vacuoles. These blasts are like those found in Burkitt’s lymphoma. This variety is rare.
Chromosomes:
Chromosome abnormalities occur in approximately one-half. Hyperdiploidy is associated with favorable prognosis. The presence of the Philadelphia chromosome t(9;22) is a poor prognostic feature and is found in 10-30% of adult cases.
Most cases have the phenotype of immature B cells and are positive for:
- Terminal deoxynucleotidyl transferase (TdT)
- HLA-DR
- CD19
- Common ALL antigen (CD10)
About 10% of cases have an early T-cell phenotype (TdT positive, HLD-DR negative, CD10 positive or negative, anti-T cell antibodies positive, e.g. cytoplasmic CD3, CD7.
Treatment:
Treatment recommendations for patients who are diagnosed with ALL include supportive treatment, induction, consolidation and maintenance therapy along with CNS prophylaxis.
- Supportive treatment includes transfusion for anemia, treatment of infections, platelets for bleeding, and social and psychological support. Patients should receive leucodepleted, irradiated blood products to reduce the risk of transfusion-associated graft versus host disease, cytomegalovirus (CMV) transmission, and febrile transfusion reactions. Patients usually receive packed red cells when the hemoglobin level falls below 8 g/dL, those with significant respiratory and cardiac disease might require transfusion at a higher hemoglobin level. Patients receive platelet transfusions when the platelet count is <10,000/mm3. Patients with active bleeding will be transfused to a platelet count of 50,000/mm3; patients with CNS hemorrhage should be transfused to a platelet count of 100,000/mm3.
- Patients receive remission induction therapy with combinations of drugs, including vincristine, prednisone, cyclophosphamide, daunorubicin, and L-asparaginase, which are given over 4-6 weeks. Remission is obtained in over 90% of children and in 70-90% of adults. Remission is defined as a normal blood count with less than 5% blasts in the bone marrow.
- Patients then receive consolidation (intensification) with multiagent therapy additionally, including cytarabine and methotrexate.
- Maintenance therapy includes 6-mercaptopurine, methotrexate, steroids, and vincristine; intrathecal methotrexate is administered throughout.
- Newer studies with intensive multiagent chemotherapy (ie, the CALGB [Cancer and Leukemia Group B]- 8811 and hyper-CVAD [hyperfractionated cyclophosphamide, vincristine, doxorubicin, and dexamethasone] regimens and the ALL-2 regimen) plus the addition of tyrosine kinase inhibitors (TKIs) for Philadelphia chromosome–positive ALL and rituximab for CD20-positive ALL have resulted in 3-year survivals of 50% or more in adults.
- Recent advances in immunotherapy have significantly improved outcomes in Acute Lymphoblastic Leukemia (ALL), particularly for relapsed or refractory disease. Blinatumomab, a bispecific T-cell engager (BiTE) antibody targeting CD19, has become a cornerstone in modern ALL management by redirecting cytotoxic T cells to eliminate malignant B-lymphoblasts. It demonstrates high rates of minimal residual disease (MRD) clearance and is increasingly used both in salvage therapy and as a bridge to allogeneic stem cell transplantation. Inotuzumab ozogamicin, an anti-CD22 antibody–drug conjugate, delivers a potent cytotoxic payload directly into leukemic blasts, resulting in deep and rapid remissions with favorable tolerability. These targeted immunotherapies offer effective options for patients who do not respond to conventional chemotherapy and are reshaping the therapeutic landscape of ALL by expanding curative possibilities and improving survival across risk groups.

Blinatumomab (Blincyto) is a key immunotherapy agent used in relapsed or refractory Acute Lymphoblastic Leukemia (ALL).

Inotuzumab ozogamicin (Besponsa) is an effective targeted therapy for relapsed or refractory Acute Lymphoblastic Leukemia (ALL).
- Stem cell transplantation represents the most intensive post-remission therapy and potentially increases a patient’s chance for cure. Although autologous stem cell transplantation has lower treatment-related mortality than allogeneic transplantation, the relapse rate is higher than for patients receiving allogeneic stem cell transplantation. However, patients undergoing allogeneic stem cell transplantation frequently develop complications from graft versus host disease that can affect long-term survival as well as the quality of life.
Prognosis:
Prognostic factors help determine treatment protocol and intensity.
Favorable prognostic factors are:
- Age 3 to 9 years.
- WBC count <25,000/mm3 (< 50,000/mm3 in children).
- French-American-British (FAB) L1 morphology.
- Leukemic cell karyotype with > 50 chromosomes and t(12;21).
- No CNS disease at diagnosis.
Unfavorable prognostic factors are:
- A leukemic cell karyotype with chromosomes that are normal in number but abnormal in morphology (pseudodiploid).
- Presence of the Philadelphia (Ph) chromosome t(9;22).
- Increased age in adults (age older than 30 years).
- B-cell immunophenotype with surface or cytoplasmic immunoglobulin.
- Early precursor T-cell phenotype; BCR-ABL–like molecular signature.
Summary:
Acute Lymphoblastic Leukemia (ALL) is an aggressive hematologic malignancy characterized by uncontrolled proliferation of lymphoblasts in the bone marrow and blood. It is the most common childhood cancer, peaking between ages 2 and 5, yet also affects adults with distinct biological and prognostic features. ALL typically presents with symptoms of marrow failure, lymphadenopathy, hepatosplenomegaly, and, in T-cell cases, anterior mediastinal masses. Diagnosis relies on morphology, immunophenotyping, cytogenetics, and molecular testing, including evaluation for Philadelphia chromosome–positive disease. Treatment involves risk-adapted multi-agent chemotherapy with defined phases—induction, consolidation, CNS prophylaxis, and maintenance—with consideration of stem cell transplantation in high-risk patients. Advances in targeted therapy, tyrosine kinase inhibitors, and immunotherapies such as blinatumomab and inotuzumab ozogamicin continue to improve survival outcomes. Early recognition, accurate classification, and timely initiation of therapy are essential for optimal management of ALL.
Questions and Answers:
What are the early symptoms of Acute Lymphoblastic Leukemia (ALL)?
Early symptoms of ALL commonly include fatigue, pallor, fever, bone pain, bruising, bleeding, lymphadenopathy, and hepatosplenomegaly due to marrow infiltration and cytopenias.
How is Acute Lymphoblastic Leukemia diagnosed?
Diagnosis is made through blood film morphology, bone marrow aspirate showing lymphoblasts, immunophenotyping by flow cytometry, cytogenetics, and molecular testing including evaluation for BCR-ABL1.
What is the difference between ALL L1, L2, and L3?
The FAB classification differentiates lymphoblast morphology: L1 has small uniform blasts, L2 shows larger heterogeneous blasts, and L3 features deeply basophilic vacuolated blasts typical of Burkitt-type leukemia.
What imaging findings suggest T-cell ALL?
A chest X-ray showing a large anterior mediastinal mass strongly suggests T-cell ALL and may present with respiratory symptoms or superior vena cava syndrome.
What is the prognosis of childhood ALL?
Childhood ALL has an excellent prognosis, with cure rates exceeding 85% due to modern risk-adapted chemotherapy, immunotherapy, and CNS-directed prophylaxis.
How is Philadelphia chromosome–positive ALL treated?
Ph-positive ALL is treated with tyrosine kinase inhibitors (such as imatinib or dasatinib) combined with chemotherapy, often followed by allogeneic stem cell transplantation in eligible patients.
What is minimal residual disease (MRD) in ALL?
MRD refers to the presence of small numbers of leukemic cells detectable by flow cytometry or PCR, and it is the most powerful prognostic marker guiding risk stratification and treatment intensity.
How does blinatumomab work in treating ALL?
Blinatumomab is a CD19-directed bispecific T-cell engager that activates the patient’s own T cells to target and destroy B-lymphoblasts, achieving high MRD clearance and deep remissions.
When is inotuzumab ozogamicin used in ALL?
Inotuzumab ozogamicin is used in relapsed or refractory B-cell ALL and delivers a cytotoxic agent directly into CD22-positive blasts to induce rapid remission.
What are the main phases of ALL chemotherapy?
Treatment includes induction to achieve remission, consolidation and intensification to eliminate residual disease, CNS prophylaxis, and prolonged maintenance therapy to prevent relapse.
Can adults develop Acute Lymphoblastic Leukemia?
Yes, adults can develop ALL, though it is less common than in children. Adult ALL has different biological characteristics and often requires more intensive therapy.
What are the complications of ALL?
Complications include infections, bleeding, tumor lysis syndrome, anemia, thrombocytopenia, leukostasis, and treatment-related toxicities.
How is CNS involvement detected in ALL?
CNS involvement is assessed by lumbar puncture with cerebrospinal fluid analysis and may require MRI if neurological symptoms are present.
What factors influence prognosis in ALL?
Prognostic factors include age, WBC count at diagnosis, cytogenetics (e.g., BCR-ABL1, ETV6-RUNX1, KMT2A rearrangements), MRD status, and response to initial therapy.
Can an anterior mediastinal mass cause symptoms in ALL?
Yes, especially in T-cell ALL, where a bulky mediastinal mass may cause cough, dyspnea, chest pain, or superior vena cava obstruction.
References:
American Cancer Society. Cancer Facts & Figures 2016. Available from: https://www.cancer.org/
NCCN Clinical Practice Guidelines. Acute Lymphoblastic Leukemia. Version 2.2015. National Comprehensive Cancer Network. Available from: https://www.nccn.org/
Karen Seiter, Francisco Talavera, Ronald A. Sacher, Clarence Sarkodee Adoo, et al. Acute Lymphoblastic Leukemia: Practice Essentials, Background, Pathophysiology. Medscape. Available from: https://emedicine.medscape.com/article/207631-overview
Michael E. Rytting, MD. Acute Lymphocytic Leukemia (ALL). Merck Manuals Professional Edition. Available from: https://www.merckmanuals.com/
Czuczman MS, Dodge RK, Stewart CC, Frankel SR, Davey FR, Powell BL, et al. Value of immunophenotype in intensively treated adult ALL: Cancer and Leukemia Group B study 8364. Blood. 1999;93(11):3931–3939.
Preti HA, Huh YO, O’Brien SM, Andreeff M, Pierce ST, Keating M, et al. Myeloid markers in adult ALL: correlations with disease characteristics and prognosis. Cancer. 1995;76(9):1564–1570.
Fiere D, Archimbaud E, Extra JM, Marty M, David B, Witz F, et al. Treatment of adult ALL: preliminary results from the French Group trial. Haematol Blood Transfus. 1987;30:125–129.
Durrant IJ, Prentice HG, Richards SM. Intensification of treatment for adult ALL: results of UKALL XA randomized trial. Br J Haematol. 1997;99(1):84–92.
Kantarjian H, Thomas D, O’Brien S, Cortes J, Giles F, Jeha S, et al. Long-term follow-up of Hyper-CVAD regimen in adult ALL. Cancer. 2004;101(12):2788–2801.
Thomas DA, Faderl S, Cortes J, O’Brien S, Giles FJ, Kornblau SM, et al. Hyper-CVAD plus imatinib for Ph-positive ALL. Blood. 2004;103(12):4396–4407.
Weisdorf DJ, Billett AL, Hannan P, Ritz J, Sallan SE, Steinbuch M, et al. Autologous vs unrelated donor allogeneic marrow transplantation in ALL. Blood. 1997;90(8):2962–2968.
Pui C-H, Evans WE. Treatment of Acute Lymphoblastic Leukemia. N Engl J Med. 2006;354:166–178.
https://www.nejm.org/doi/full/10.1056/NEJMra052603
Hunger SP, Mullighan CG. Acute Lymphoblastic Leukemia in Children. N Engl J Med. 2015;373:1541–1552.
https://www.nejm.org/doi/full/10.1056/NEJMra1400972
Keywords:
Acute Lymphoblastic Leukemia, ALL symptoms, ALL diagnosis, childhood ALL, adult ALL, T-cell ALL, B-cell ALL, mediastinal mass ALL, lymphoblasts, bone marrow lymphoblasts, Philadelphia chromosome ALL, BCR-ABL1 ALL, ALL treatment, induction therapy ALL, consolidation therapy ALL, Hyper-CVAD, MRD in ALL, ALL prognosis, ALL chemotherapy phases, immunotherapy for ALL, blinatumomab ALL, inotuzumab ozogamicin ALL, CAR-T therapy ALL, bone marrow transplant ALL, relapsed ALL, refractory ALL, cytogenetics ALL, flow cytometry ALL, FAB classification ALL, ALL survival rates, leukemia in children, leukemia in adults.


Request Online Consultation With Dr M Abdou
Fee: US$100
Secure payment via PayPal (credit and debit cards accepted)
Pay Now